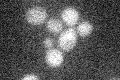
YKL001C
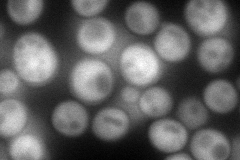
YKL001C
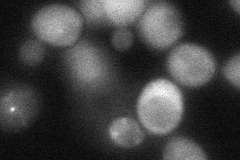
YKL001C
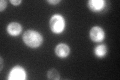
YKL001C

View description
Adenylylsulfate kinase, required for sulfate assimilation and involved in methionine metabolism
Localization:
Intensity:
Fold change:
Significance:
-
C’ GFP library in SD
below threshold16.99 -
N' NOP1pr-GFP in SD
cytosol128.701 -
N' TEF2pr-mCherry in SD

cytosol221.724 -
N' NATIVEpr-GFP in SD

cytosol24.6054 -
N' TEF2pr-VC and Cyto-VN in SD
cytosol51.4415 -
C’ GFP library in SD+DTT

cytosol21.151.24No -
C’ GFP library in SD+H2O2

cytosol19.191.12No -
C’ GFP library in Starvation Media
nucleus220.8112.99No -
C’ GFP library on the background of Pup2-DaMP

below threshold -
C’ GFP library on the background of CCT mutant

below threshold17.05051.00305No
